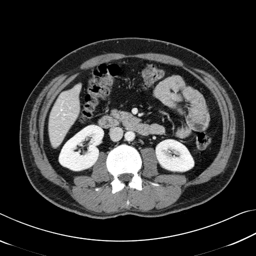

In many clinical settings, the use of both Computed Tomography (CT) and Magnetic Resonance (MRI) is necessary to pursue a thorough understanding of the patient's anatomy and to plan a suitable therapeutical strategy; this is often the case in MRI-based radiotherapy, where CT is always necessary to prepare the dose delivery, as it provides the essential information about the radiation absorption properties of the tissues. Sometimes, MRI is preferred to contour the target volumes. However, this approach is often not the most efficient, as it is more expensive, time-consuming and, most importantly, stressful for the patients. To overcome this issue, in this work, we analyse the capabilities of different configurations of Deep Learning models to generate synthetic CT scans from MRI, leveraging the power of Generative Adversarial Networks (GANs) and, in particular, the CycleGAN architecture, capable of working in an unsupervised manner and without paired images, which were not available. Several CycleGAN models were trained unsupervised to generate CT scans from different MRI modalities with and without contrast agents. To overcome the problem of not having a ground truth, distribution-based metrics were used to assess the model's performance quantitatively, together with a qualitative evaluation where physicians were asked to differentiate between real and synthetic images to understand how realistic the generated images were. The results show how, depending on the input modalities, the models can have very different performances; however, models with the best quantitative results, according to the distribution-based metrics used, can generate very difficult images to distinguish from the real ones, even for physicians, demonstrating the approach's potential.
翻译:暂无翻译